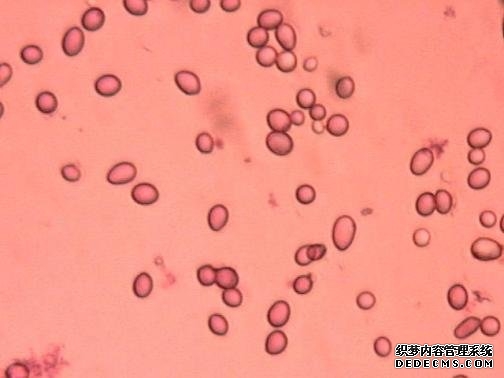

|
播报 编辑  霉菌孢子各种形态图(3张) 霉菌的孢子具有小、轻、干、多以及形态色泽各异、休眠期长和抗逆性强等特点。霉菌孢子形态常有球形、卵形、椭圆形、礼帽形、土星型、肾形、线形、镰刀形等 [4]。霉菌孢子很小,直径只有0.01mm-0.1mm [5]。每个个体所产生的孢子数量,经常是成千上万的,有时竟然达到几百亿、几千亿,甚至更多。孢子的这些特点,都有助于真菌在自然界中随机散播和繁殖 [4]。 霉菌菌落最初常呈浅色或白色,当长出各种颜色的孢子后,相应呈现黄、绿、青、棕、橙、黑等各色,这是由于孢子有不同形状、构造与色素所致。 [6] 有的霉菌孢子在-150℃仍能生存,高温170℃干热或110℃湿热才能将它杀死。 [5] 播报 编辑 无性孢子是霉菌进行繁殖的主要方式。这些孢子有如下几种。 [6] 节孢子( arthrospore) 节孢子由菌丝断裂而成,又称粉孢子或裂孢子。节孢子的形成过程是菌丝生长到一定阶段,菌丝上出现许多横隔,然后从横隔处断裂,产生许多形如短柱状、筒状或两端呈钝圆形的节孢子。 [6] 游动孢子( zoospore) 游动孢子产生在由菌丝膨大而成的游动孢子囊内,孢子通常为圆形、洋梨形或肾形,具一根或两根鞭毛,能够游动。鞭毛的亚显微结构为9+2型,产生游动孢子的真菌多为水生真菌,大多数为鞭毛菌亚门的真菌。 [6] 厚垣孢子( chlamydospore) 厚垣孢子又称厚壁孢子。它是由菌丝中间(少数在顶端)的个别细胞膨大,原生质浓缩和细胞壁变厚而形成的休眠孢子。厚垣孢子呈圆形、纺锤形或长方形,它是霉菌度过不良环境的一种休眠细胞,寿命较长,菌丝体死亡后上面的厚垣孢子还活着,一旦环境条件好转就能萌发成菌丝体。 [6] 孢囊孢子( sporangiospore)  孢囊孢子 孢囊孢子孢囊孢子圆形,无鞭毛、不能运动,在空中随风飘荡,遇到适宜的环境,可萌发并形成新的菌丝体。 [6] 分生孢子( conidiospora) 分生孢子是霉菌中常见的一类无性孢子,是生于菌丝细胞外的孢子,所以称为外生孢子。分生孢子着生于已分化的分生孢子梗或具有一定形状的小梗上,也有些真菌的分生孢子就着生在菌丝的顶端。 [6] 曲霉(Aspergillu.s)和青霉(Penicillium)大多以分生孢子萌发为菌丝体,在气生菌丝上产生分生孢子梗,在分生孢子梗上串生许多分生孢子,分生孢子在适宜的环境中萌发为菌丝体。 [6] 霉菌有性繁殖靠产生有性孢子进行。真菌有性孢子是经过两个性细胞或菌丝的结合而形成的。有性孢子的形成过程一般经过质配、核配和减数分裂3个阶段。常见的真菌有性孢子有卵孢子、接合孢子、子囊孢子和担孢子。 [6] 卵孢子( oospore) 卵孢子是由两个大小不同的配子囊结合发育而成的。小型配子囊称为雄器,大型的配子囊称为藏卵器,藏卵器中的原生质与雄器配合以前,收缩成一个或数个原生质团,称卵球。当雄器与藏卵器配合时,雄器中的细胞质和细胞核通过受精管而进入藏卵器与卵球配合,此后卵球生出外壁即成为卵孢子,卵孢子的数量取决于卵球的数量。 [6] 接合孢子( zygospore) 接合孢子是由菌丝生出的形态相同或略有不同的配子囊( gametangium)接合而成的。接合孢子的形成过程是两个相邻的菌丝相遇,各自向对方生出极短的侧枝,称为原配子囊(progametangium)。原配子囊接触后,顶端各处膨大并形成横隔,即为配子囊,配子囊下面的部分称为配囊柄( suspensor)。相接触的两个配子囊之间的横隔消失,其细胞质与细胞核互相配合,同时外部形成厚壁,即为接合孢子。适宜的条件下,接合孢子可萌发成新的菌丝体。 [6] 子囊孢子 子囊孢子形成于子囊中,先是同一菌丝或相邻的两菌丝上的两个大小和形状不同的性细胞互相接触并互相缠绕。接着两个性细胞经过受精作用后形成分枝的菌丝,称为造囊丝。造囊丝经过减数分裂,产生子囊。每个子囊产生2-8个子囊孢子。在子囊和子囊孢子发育过程中,原来的雄器和藏卵器下面的细胞生出许多菌丝,它们有规律地将产囊丝包围,于是形成了子囊果。子囊果有3种类型:第一种为完全封闭圆球形,称为闭囊壳;第二种有孔,称为子囊壳;第三种呈圆盘状,称为子囊盘。 [6] 担孢子( basidiospore)  囊孢子与担孢子 囊孢子与担孢子播报 编辑 霉菌生存于湿润温暖的环境中,但孢子几乎可以生存在任何环境中,当条件适宜时,它们就会迅速生长繁殖。 [7] 播报 编辑 霉菌孢子 霉菌孢子播报 编辑 1.印片法观察  孢子梗 孢子梗(2)将印有孢子的一面朝下,放在滴有一滴美蓝染液的载玻片上,静置3min,使放线菌和霉菌孢子可着色。 (3)用油镜观察孢子的形态结构。 [9] 2.凹玻片法观察 (1)取一灭菌的凹玻片,于凹窝内滴加少量熔化的固体培养基,待凝。 (2)接种少许菌种,覆盖一灭菌的盖玻片,盖玻片与凹窝间稍留一点空隙以便通气。 (3)将凹玻片置无菌平皿内,皿内垫一块潮湿的脱脂棉以维持湿度,25-28℃恒温培养3天。观察生长状况。 [9] 3.盖玻片法观察 (1)将菌种均匀的涂布在固体平板培养基上。 (2)用镊子夹一张无菌盖玻片斜插入平板内的培养基中,插入深度为盖玻片高度的1/2或1/3。 (3) 25-28℃恒温箱中培养5-7天。 (4)用镊子取出盖玻片放在载玻片上,用低倍镜或高倍镜观察菌丝及孢子的情况。 [9] 播报 编辑 由于不同种属的霉菌产生孢子的方式、孢子的形态或产生孢子的器官不同,所以霉菌孢子的形态特征和产孢子器官的特征是霉菌分类、鉴定的主要依据。 [2] 播报 编辑  霉菌孢子(5张) 空气中飘浮着的霉菌孢子经常掉落在有机物上,如木制品、纤维制品、皮革制品等。霉菌还经常附着在天花板、墙壁、家具和窗帘上,对这些家具造成损害。空气中的霉菌孢子还会飘落在食物上,然后在食物上萌芽、发育、繁殖,继而令食物腐败发臭,甚至产生毒素。在谷物、豆类上的霉菌所产生的黄曲霉菌毒素经常会引起食物中毒,甚至会造成肾脏损害和癌症。飘浮在空气中的霉菌孢子若是落在人体皮肤黏膜上就可能会导致体癣。霉菌还会导致过敏。霉菌孢子及其代谢物经常会导致哮喘、荨麻疹、过敏性鼻炎等。 [11] 当宠物机体免疫力较低时,则有可能通过吸收霉菌的分生孢子而造成感染,所以宠物极易发生曲霉菌病。曲霉菌孢子可穿过禽类蛋壳而导致胚胎死亡。 [12] 空气中的霉菌孢子主要来自尘埃,它们附着于尘埃小粒和雾气小滴中。这些霉菌孢子常常因空气稍微流动而飘浮,一旦落在档案上,如条件适宜便迅速生长繁衍,造成档案材料霉变。 [13]
(责任编辑:admin666) |
